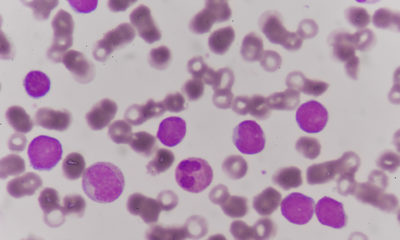

Все статьи с тегом "#СамоеВремяЖить"
-
ЗаболеванияФонд борьбы с лейкемией запускает информационный портал для людей с раком крови
Портал #СамоеВремяЖить станет первой в России виртуальной библиотекой знаний об онкологических заболеваниях кроветворной системы.
«PRO Здоровье» 28.04.2021
Крутите вниз
Жмите
-
Мир звуков: простые шаги к лучшему восприятию речи и музыкиЗаболевания25.03.2022
-
Невидимые болезни под прицелом: как МРТ находит опухоли на ранней стадииЗаболевания27.03.2022
-
Кодирование от алкоголизма: особенности процедуры, разновидности и преимуществаЗависимость, вредные привычки31.03.2023
-
УЗИ печени: когда проводится и для чего необходимоЗаболевания19.05.2022
-
Уколы красоты: 10 самых популярных и эффективных инъекционных процедурКосметология19.05.2022
-
Ступени жизни: открытие арт-объекта в поддержку пациентов с муковисцидозомЗаболевания06.07.2021
-
Ночные линзы для восстановления зрения — сколько стоят?Лекарственные средства и препараты, медицинское оборудование16.04.2022
-
Когда можно мочить брови после перманентного макияжаКосметология22.12.2021
-
Как защитить себя и своих близких от ротавирусной инфекции и не испортить летний отдыхЗаболевания20.07.2021
-
Как отличить родинку от папилломыЗаболевания29.10.2021
-
В России наблюдается серьезный дефицит медицинских психологовПсихология и здоровье23.11.2021
-
Основные правила хорошего петтинга.Он и Она01.07.2024
-
Врач «Инвитро» рассказал, как правильно начинать заниматься спортомАктивный образ жизни30.09.2021
-
5 простых советов, которые помогут привлечь внимание на сайте знакомствОн и Она27.04.2022
-
Стоматология «Кристалл» в Череповце: как выбрать клинику и понять, за что вы платитеСтоматология04.06.2026
-
Как правильно выбрать зубную пасту — советы экспертаСтоматология02.06.2026
-
Почему даже любимое дело надоедает — объясняет экспертПсихология и здоровье01.06.2026
-
Цифровая эпоха усиливает одиночество: взгляд психологаПсихология и здоровье01.06.2026
-
Причины и лечение регулярной икоты: объясняет профессор Пироговского УниверситетаКонсультации специалистов01.06.2026
-
Важные привычки для тела и мозга — советы экспертаБыть здоровым29.05.2026
-
От амниотической жидкости до тарелки: как формируются пищевые привычки по данным экспертаЕда, продукты питания27.05.2026
-
Никотин — главная опасность. Судебно-медицинский эксперт Пироговского Университета разрушает мифыЗависимость, вредные привычки27.05.2026
-
Роль витаминов в работе нервной системы — объясняет специалистЛекарственные средства и препараты, медицинское оборудование27.05.2026

Odnoklassniki
VKontakte
Telegram
RSS